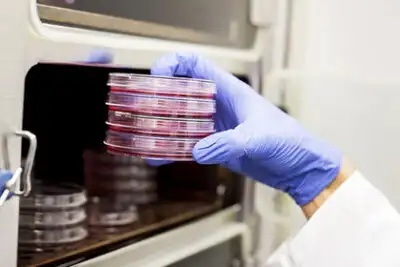

Исследователи Школы медицины Маунт-Синай (США) создали новый способ иммунотерапии рака, что оказывает помощь остановить развитие очень агрессивного и трудноизлечимого рака крови. Об этом информирует издание Science Alert.
В базе способа лежит кросс-презентация антигена. На протяжении простой презентации иммунные клетки, именуемые дендритными клетками, захватывают антиген (чужеродный компонент) и воображают его Т-лимфоцитам, в следствии чего последние начинают распознавать антиген и атакуют носители последнего. Антиген представляется совместно с молекулами комплекса гистосовместимости (MHC) на поверхности дендритных клеток. Внутриклеточные антигены в большинстве случаев находятся в связке с MHC класса I, а внеклеточные — с MHC класса II.
При кросс-презентации внутриклеточные антигены представляются как внеклеточные. Для терапии трудноизлечимой разновидности рака крови — неходжкинской лимфомы — исследователи применяли последовательность стимуляторов. Один из стимуляторов заставляет дендритные клетки мигрировать к злокачественным тканям, а второй содействует представлению антигенов, каковые в этом случае являются опознавательными символами лимфомы.
В опробовании вакцины участвовали 11 больных на поздних стадиях прогрессирования рака. В следствии терапия усилила активность Т-лимфоцитов и привела к иммунным реакциям далеко от места вакцинации. Помимо этого, опыты на мышах показала повышение эффективности процедуры при комбинировании с способом ингибирования контрольных точек. Часть ремиссии заболевания в этом случае повысилась с 40 до 80 процентов.
Не так давно мне рассказали, что в магазине – novicam66.ru возможно выбрать и купить готовый комплект видеонаблюдения, множество преимуществ достаточно хорошо описаны. Цены достаточно низкие! Воспользуйтесь такой возможностью!